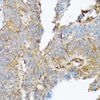

NCX1 (SLC8A1) Rabbit Polyclonal Antibody
Other products for "SLC8A1"
Specifications
| Product Data | |
| Applications | IHC, WB |
| Recommended Dilution | WB,1:1000 - 1:2000 IHC,1:50 - 1:200 |
| Reactivities | Human, Mouse, Rat |
| Modifications | Unmodified |
| Host | Rabbit |
| Isotype | IgG |
| Clonality | Polyclonal |
| Immunogen | Recombinant fusion protein containing a sequence corresponding to amino acids 250-520 of human SLC8A1 (NP_066920.1). |
| Formulation | Buffer: PBS with 0.02% sodium azide,50% glycerol,pH7.3. |
| Concentration | lot specific |
| Purification | Affinity purification |
| Conjugation | Unconjugated |
| Storage | Store at -20℃. Avoid freeze / thaw cycles. |
| Stability | Shelf life: one year from despatch. |
| Predicted Protein Size | 104kDa/107kDa/108kDa |
| Gene Name | solute carrier family 8 member A1 |
| Database Link | |
| Background | In cardiac myocytes, Ca(2+) concentrations alternate between high levels during contraction and low levels during relaxation. The increase in Ca(2+) concentration during contraction is primarily due to release of Ca(2+) from intracellular stores. However, some Ca(2+) also enters the cell through the sarcolemma (plasma membrane). During relaxation, Ca(2+) is sequestered within the intracellular stores. To prevent overloading of intracellular stores, the Ca(2+) that entered across the sarcolemma must be extruded from the cell. The Na(+)-Ca(2+) exchanger is the primary mechanism by which the Ca(2+) is extruded from the cell during relaxation. In the heart, the exchanger may play a key role in digitalis action. The exchanger is the dominant mechanism in returning the cardiac myocyte to its resting state following excitation. |
| Synonyms | CNC; DKFZp779F0871; FLJ37694; FLJ43417; MGC119581; NCX1; OTTHUMP00000128378; OTTHUMP00000201569; OTTHUMP00000201570; OTTHUMP00000201587; OTTHUMP00000201589 |
| Reference Data | |
Documents
| Product Manuals |
| FAQs |
| SDS |
{0} Product Review(s)
0 Product Review(s)
Submit review
Be the first one to submit a review
Product Citations
*Delivery time may vary from web posted schedule. Occasional delays may occur due to unforeseen
complexities in the preparation of your product. International customers may expect an additional 1-2 weeks
in shipping.






























































































































































































































































 Germany
Germany
 Japan
Japan
 United Kingdom
United Kingdom
 China
China